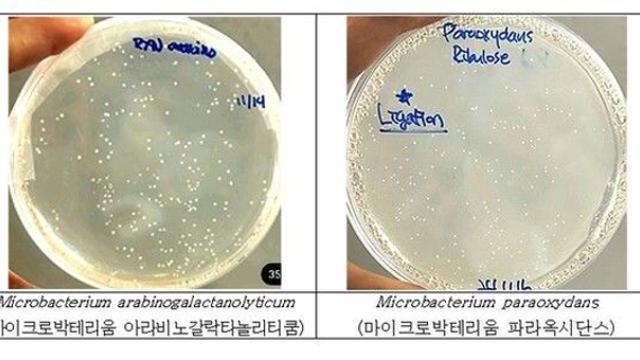
thumbimg

뉴스
- 거제 해상서 멸치잡이 조업중 외국인 선원 2명 부상…1명 해상추락
- 모두서치 2025.08.07
- 사진 = 뉴시스 7일 오전 8시31분께 경남 거제시 일운면 외도 남서방 약 2㎞ 해상에
- "유전자 변형 없는 미생물로 '알룰로스' 생산기반 마련"
- 모두서치 2025.08.07
- 사진 = 뉴시스 국립낙동강생물자원관이 과당을 유전자변형 없이 알룰로스로 전환할 수 있는
- 교보생명 창립 67주년…신창재 의장 “고객 중심 경영” 강조
- 투데이신문 2025.08.07
- 신창재 교보생명 의장 [사진=교보생명] 【투데이신문 김효인 기자】 신창재 교보생명 대표이사
- 삼성전자, 애플 파운드리 고객 확보…텍사스서 혁신 칩 생산
- 투데이신문 2025.08.07
- 애플 팀 쿡 최고경영자(CEO)가 6일(현지 시간) 백악관 집무실에서 애플의 대미 시설 투
- `괴물폭우`에도 환불 NO…펜션·캠핑장 갑질에 소비자 `발 동동`
- 이데일리 2025.08.07
- [이데일리 방보경 기자] 폭우와 폭염이 반복되는 올 여름 피서객들의 고민이 커지고 있다.
- 놀유니버스, 여가시장 AI 혁신 위해 테크 인재 대규모 채용
- 비즈니스플러스 2025.08.07
- 사진=놀유니버스 놀유니버스는 AI와 디지털 중심의 여행·여가 생태계 조성을 위해 테크 분야
- bhc, 말복 맞아 소비쿠폰·앱 프로모션 확대
- 일간스포츠 2025.08.07
- bhc가 오는 8월 9일 말복을 앞두고 무더위 속 소비자들의 외식 수요에 맞춰 소비쿠폰과
- LG화학, 에스테틱 사업 2000억에 매각
- 아주경제 2025.08.07
- LG화학 CI [사진=LG화학] LG화학은 7일 생명과학사업본부 내 에스테틱 사업을 매각한
- 혐의 소명됐나…특검, 소환 하루만에 김건희 구속영장 청구
- 이데일리 2025.08.07
- [이데일리 송승현 기자] 민중기 특별검사팀이 7일 김건희 여사에 대한 구속영장을 청구했다.
- 자동차 침수돼도… '이럴 경우' 보상 한 푼도 못 받을 수 있습니다
- 위키트리 2025.08.07
- 최근 전국적으로 기록적인 폭우가 이어지고 있는 가운데, 자동차 침수 피해 시 보험 보상 가
- BAT로스만스, 2025년 하반기 신입사원 공개 채용 실시
- 비즈니스플러스 2025.08.07
- 사진= BAT 던힐, 글로 뷰즈 등을 전개하는 글로벌 기업 BAT로스만스가 2025년 하반
- 대한항공, 방산기업 안두릴과 아·태지역 무인기 개발 사업 협력키로
- 일간스포츠 2025.08.07
- 협약식에 참석한 임진규 대한항공 항공우주사업본부장(오른쪽)과 팔머 럭키 안두릴 창업자(왼
- 박민준군(박승원 광명시장·신지희씨 장남)·오수현양(오태욱·김숙자씨 딸)
- 경기일보 2025.08.07
- ▲박민준군(박승원 광명시장·신지희씨 장남)·오수현양(오태욱·김숙자씨 딸)=16일 오후 3시
- “사람을 사람답게, 복지의 온기를 잇다”...이재경 시흥 거모종합사회복지관장
- 경기일보 2025.08.07
- 이재경 시흥 거모종합사회복지관장. 김형수기자 “변화를 두려워하지 않고 도전을 이어가는
- 제네시스, 부산국제영화제 9년 연속 후원
- 일간스포츠 2025.08.07
- (왼쪽부터) 현대차 국내사업본부장 정유석 부사장, 부산국제영화제 박광수 이사장이 기념사진
- 현대백화점 판교점, 로블록스 팝업스토어에서 공식 굿즈 판매
- 비즈니스플러스 2025.08.07
- 사진=현대백화점 현대백화점은 오는 17일까지 판교점 지하 1층 대행사장 및 10층 토파즈홀
- 베트남 '서열 1위' 당서기장 국빈 방한…이 대통령과 11일 정상회담
- 모두서치 2025.08.07
- 사진 = 뉴시스 베트남 권력 서열 1위인 또 럼 베트남 공산당 서기장이 이재명 대통령
- 문양목 지사 등 독립유공자 유해, 광복 80년 만에 조국 품으로
- 모두서치 2025.08.07
- 사진 = 뉴시스 머나먼 이국 땅에 안장된 독립유공자 6명의 유해가 광복 80년 만에 조
- "불끄고 스마트폰 보신다구요?"…실명주범 '이것' 올수도
- 모두서치 2025.08.07
- 사진 = 뉴시스 최근 황반변성, 당뇨망막병증과 함께 3대 실명질환으로 꼽히는 녹내장 환
- 펄어비스 붉은사막, ‘게임스컴 2025’에서 새 시연 버전 공개
- 이뉴스투데이 2025.08.07
- 펄어비스 붉은사막 이미지. [사진=펄어비스] [이뉴스투데이 백연식 기자] 펄어비스가 오는

경기
경상원 김민철 원장, 안성·의왕 등 ‘통큰 세일’ 현장 방문…“민생 회복의 도약 ...
김기보 / 25.11.27

제주
제주도 상하수도본부 하수도사업 하도급업체 애로사항 청취
김영란 / 25.11.27

대구/경북
김천시 시설관리공단, 25년 대구·경북 일자리 창출 기여, 한국노인인력개발원장 우...
김지훈 / 25.11.27

경기
경기도의회 건설교통위원회, 정당 초월 ‘민생중심’ 예산안 심사 맞손
김기보 / 25.11.27